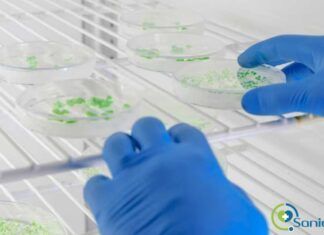
tipos de estufas de laboratorio

Innovación y calidad en suministros de productos farmacéuticos
En el campo de la industria farmacéutica, contar con un proveedor de confianza para el suministro de productos es de vital importancia. Los productos farmacéuticos requieren...
Creando tu laboratorio desde cero: Todo lo que necesitas saber
Abrir las puertas a un nuevo laboratorio, ya sea para fines de investigación, pruebas, desarrollo de productos o cualquier otra labor científica, es un...
Guardando el futuro de la salud: Ciberseguridad y servicios en la nube
Estamos en plena era digital, tal es así que, incluso gran parte de los servicios médicos dependen en cierta forma del Internet y de...
Alquilar vs comprar: Los sorprendentes beneficios de alquilar equipos de laboratorio
Posiblemente los grandes olvidados de la sanidad, sean los laboratorios clínicos. Sin embargo, podemos decir con certeza que son el motor de la medicina...
La ética y la transparencia: pilares fundamentales en el marketing farmacéutico y salud
Desafortunadamente, en el ámbito empresarial, no es extraño encontrar agencias de marketing que promocionan productos o servicios cuestionables, sin tener la certeza de su...
¿Cómo elegir una agencia marketing digital para tu clínica?
El marketing online es necesario para que las clínicas de cualquier tamaño amplíen su alcance, generen interés y mejoren las ventas. Sin embargo, puede...
Todo lo que debes saber sobre los diferentes tipos de estufas de laboratorio
La investigación científica y el análisis de muestras humanas, son actividades cruciales para la humanidad porque ayuda a expandir el conocimiento y comprensión del...